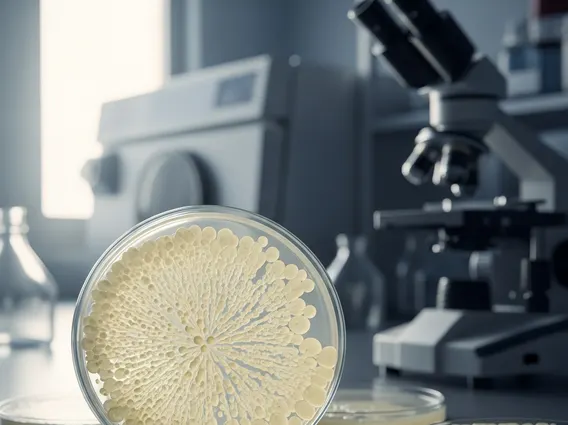

Bacteria
Bacteria are ubiquitous microorganisms that play crucial roles in various ecosystems, including the human body. Understanding their nature is fundamental to comprehending both health and disease.
Key Takeaways
- Bacteria are single-celled prokaryotic microorganisms with distinct characteristics and structures, including a cell wall, cytoplasm, and genetic material.
- They are classified by shape (cocci, bacilli, spirilla) and cell wall composition (Gram-positive, Gram-negative), inhabiting diverse environments.
- Bacteria significantly impact human health, both beneficially (e.g., aiding digestion) and detrimentally (e.g., causing infections).
- These microorganisms are found in nearly every environment on Earth, from soil and water to the human gut and skin.
What is Bacteria: Characteristics and Structure
Bacteria refers to a vast domain of single-celled, prokaryotic microorganisms that lack a membrane-bound nucleus and other internal organelles. They are among the earliest life forms on Earth and are found in almost every habitat. Their microscopic size, typically a few micrometers in length, belies their profound impact on global ecosystems and human health.
The fundamental characteristics of bacteria include their prokaryotic cell structure, rapid reproduction through binary fission, and metabolic diversity. Their basic structure comprises a cell wall, which provides shape and protection; a cell membrane, regulating substance passage; cytoplasm, where metabolic reactions occur; and a nucleoid region containing their genetic material (DNA). Many bacteria also possess flagella for motility, pili for attachment, and capsules for further protection.
Types of Bacteria and Their Habitats
Different types of bacteria are classified based on various criteria, including their shape, cell wall composition, and metabolic properties. Understanding these classifications helps in identifying and studying their diverse functions. Common classifications by shape include:
- Cocci: Spherical or oval-shaped bacteria (e.g., Streptococcus).
- Bacilli: Rod-shaped bacteria (e.g., Escherichia coli).
- Spirilla: Spiral-shaped bacteria (e.g., Spirillum minus).
Another crucial classification is based on Gram staining, which differentiates bacteria into Gram-positive (thick peptidoglycan cell wall) and Gram-negative (thin peptidoglycan layer with an outer membrane) groups. The functions of bacteria are incredibly diverse, ranging from essential roles in nutrient cycling (like nitrogen fixation) to breaking down organic matter as decomposers, and even producing vital compounds. Many also act as probiotics, supporting host health.
Common places where bacteria live are virtually limitless, demonstrating their adaptability. They thrive in soil, water bodies (oceans, rivers, lakes), and even the air. The human body is a significant habitat, with vast populations residing in the gut, on the skin, and in the mouth, forming complex microbiomes. Bacteria are also found in extreme environments such as hot springs, deep-sea vents, and highly saline lakes, showcasing their resilience.
How Bacteria Impact Human Health
Bacteria significantly impact human health in both beneficial and detrimental ways. On the beneficial side, the human microbiome, particularly in the gut, plays a critical role in digestion, synthesizing essential vitamins (like Vitamin K and certain B vitamins), and training the immune system. These commensal bacteria also form a protective barrier against pathogenic invaders.
Conversely, certain bacteria are pathogenic, meaning they can cause disease. These infections range from common ailments like strep throat and urinary tract infections (UTIs) to severe conditions such as pneumonia, tuberculosis, and sepsis. Pathogenic bacteria can cause disease through various mechanisms, including producing toxins, invading tissues, or triggering excessive inflammatory responses. A significant global health challenge is the rise of antibiotic resistance, where bacteria evolve to withstand the effects of antibiotics, making infections harder to treat. According to the World Health Organization (WHO), antibiotic resistance is one of the biggest threats to global health, food security, and development today, leading to prolonged hospital stays, higher medical costs, and increased mortality.



















